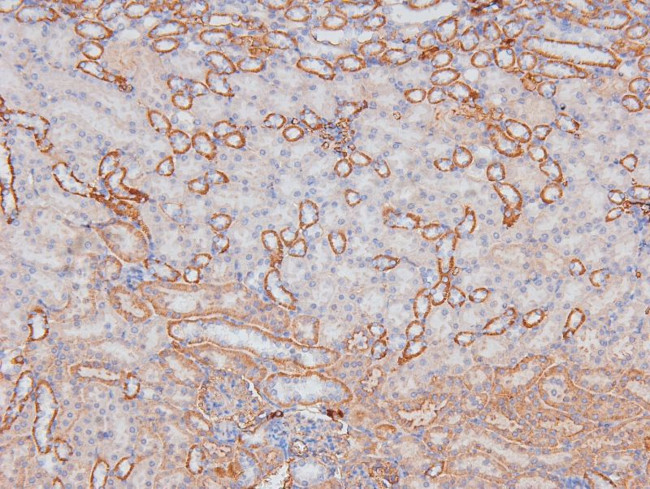
Phospho-RHOA (Ser188) Antibody in Immunohistochemistry (Paraffin) (IHC (P))

Search
Invitrogen
Phospho-RHOA (Ser188) Polyclonal Antibody
{{$productOrderCtrl.translations['antibody.pdp.commerceCard.promotion.promotions']}}
{{$productOrderCtrl.translations['antibody.pdp.commerceCard.promotion.viewpromo']}}
{{$productOrderCtrl.translations['antibody.pdp.commerceCard.promotion.promocode']}}: {{promo.promoCode}} {{promo.promoTitle}} {{promo.promoDescription}}. {{$productOrderCtrl.translations['antibody.pdp.commerceCard.promotion.learnmore']}}
图: 1 / 7
Phospho-RHOA (Ser188) Antibody (PA5-105763) in IHC (P)







Please note: We are reviewing Western blot images included in the antibody testing data in our catalog, including those provided by third parties. Unless expressly labeled or annotated as “raw-unedited”, Western blot images included in the antibody testing data in our catalog may have been edited, optimized or otherwise adjusted for presentation.
产品信息
PA5-105763
种属反应
已发表种属
宿主/亚型
分类
类型
抗原
偶联物
形式
浓度
规格
纯化类型
保存液
内含物
保存条件
运输条件
RRID
产品详细信息
Antibody detects endogenous levels of RhoA only when phosphorylated at Ser188.
靶标信息
RhoA regulates a signal transduction pathway linking plasma membrane receptors to the assembly of focal adhesions and actin stress fibers. It is involved in a microtubule-dependent signal that is required for the myosin contractile ring formation during cell cycle cytokinesis, and plays an essential role in cleavage furrow formation. RhoA is required for the apical junction formation of keratinocyte cell-cell adhesion, and serves as a target for the yopT cysteine peptidase from Yersinia pestis, vector of the plague, and Yersinia pseudotuberculosis, which causes gastrointestinal disorders. RhoA stimulates PKN2 kinase activity and may be an activator of PLCE1. It is activated by ARHGEF2, which promotes the exchange of GDP for GTP. It is essential for the SPATA13-mediated regulation of cell migration and adhesion assembly and disassembly. The MEMO1-RHOA-DIAPH1 signaling pathway plays an important role in ERBB2-dependent stabilization of microtubules at the cell cortex. It controls the localization of APC and CLASP2 to the cell membrane, via the regulation of GSK3B activity. In turn, membrane-bound APC allows the localization of the MACF1 to the cell membrane, which is required for microtubule capture and stabilization.
仅用于科研。不用于诊断过程。未经明确授权不得转售。
生物信息学
蛋白别名: aplysia ras-related homolog A; aplysia ras-related homolog A1; aplysia ras-related homolog A2; h12; MGC72339; plysia ras-related homolog A2; Ras family member A; ras homolog A1; ras homolog A2; ras homolog gene family, member A; ras homolog gene family, member A1; ras homolog gene family, member A2; Rho; Rho cDNA clone 12; Rho family GTPase; Transforming protein RhoA
基因别名: ARH12; ARHA; Arha1; Arha2; RHO12; RHOA
UniProt ID: (Rat) P61589, (Mouse) Q9QUI0
Entrez Gene ID: (Rat) 117273, (Mouse) 11848